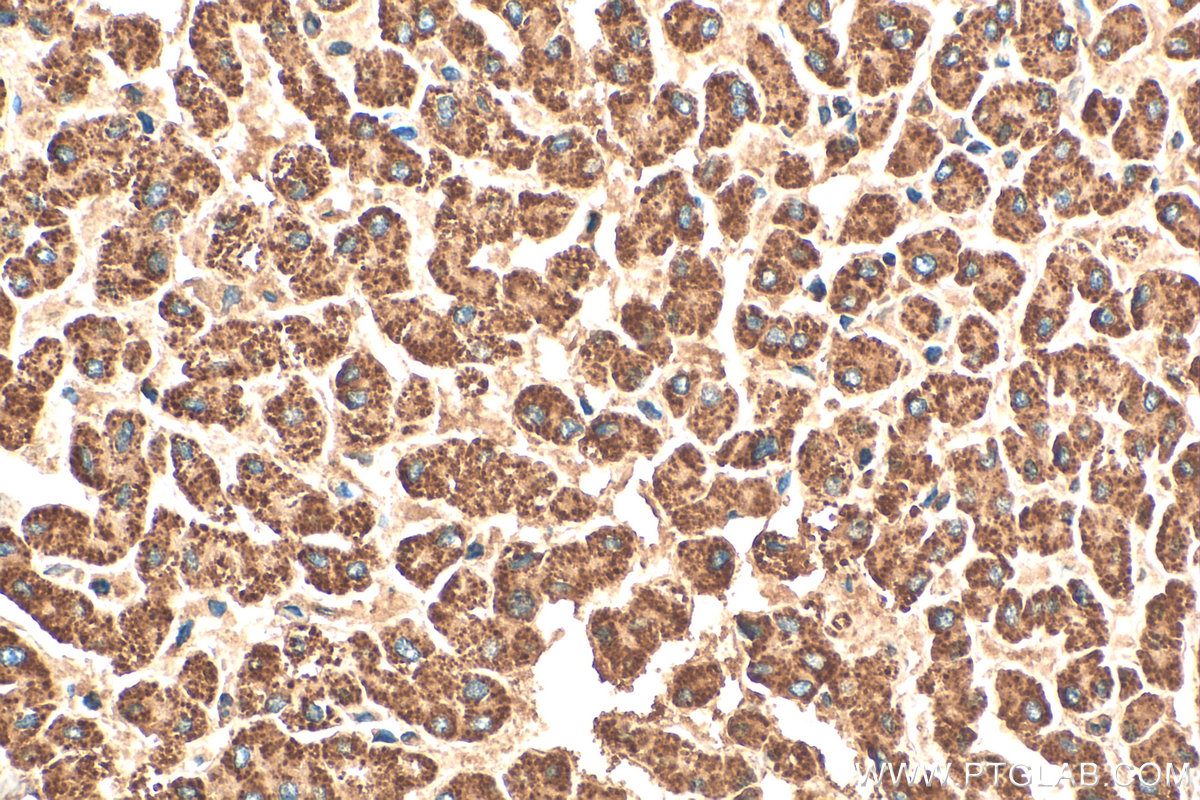
Immunohistochemical analysis of paraffin-embedded human liver tissue slide using 14930-1-AP (GCDH antibody) at dilution of 1:200 (under 40x lens). Heat mediated antigen retrieval with Tris-EDTA buffer (pH 9.0). IHC staining of human liver using 14930-1-AP

验证数据展示
经过测试的应用
| Positive WB detected in | HepG2 cells, SH-SY5Y cells |
| Positive IHC detected in | human liver tissue Note: suggested antigen retrieval with TE buffer pH 9.0; (*) Alternatively, antigen retrieval may be performed with citrate buffer pH 6.0 |
推荐稀释比
| 应用 | 推荐稀释比 |
|---|---|
| Western Blot (WB) | WB : 1:500-1:3000 |
| Immunohistochemistry (IHC) | IHC : 1:50-1:500 |
| It is recommended that this reagent should be titrated in each testing system to obtain optimal results. | |
| Sample-dependent, Check data in validation data gallery. | |
发表文章中的应用
| WB | See 4 publications below |
产品信息
14930-1-AP targets GCDH in WB, IHC, ELISA applications and shows reactivity with human samples.
| 经测试应用 | WB, IHC, ELISA Application Description |
| 文献引用应用 | WB |
| 经测试反应性 | human |
| 文献引用反应性 | human, mouse, rat |
| 免疫原 |
CatNo: Ag6713 Product name: Recombinant human GCDH protein Source: e coli.-derived, PGEX-4T Tag: GST Domain: 85-438 aa of BC002579 Sequence: LANRNEVFHREIISEMGELGVLGPTIKGYGCAGVSSVAYGLLARELERVDSGYRSAMSVQSSLVMHPIYAYGSEEQRQKYLPQLAKGELLGCFGLTEPNSGSDPSSMETRAHYNSSNKSYTLNGTKTWITNSPMADLFVVWARCEDGCIRGFLLEKGMRGLSAPRIQGKFSLRASATGMIIMDGVEVPEENVLPGASSLGGPFGCLNNARYGIAWGVLGASEFCLHTARQYALDRMQFGVPLARNQLIQKKLADMLTEITLGLHACLQLGRLKDQDKAAPEMVSLLKRNNCGKALDIARQARDMLGGNGISDEYHVIRHAMNLEAVNTYEGTHDIHALILGRAITGIQAFTASK 种属同源性预测 |
| 宿主/亚型 | Rabbit / IgG |
| 抗体类别 | Polyclonal |
| 产品类型 | Antibody |
| 全称 | glutaryl-Coenzyme A dehydrogenase |
| 别名 | ACAD5, EC:1.3.8.6, GCD, Glutaryl-CoA dehydrogenase, mitochondrial |
| 计算分子量 | 48 kDa |
| 观测分子量 | 44-48 kDa |
| GenBank蛋白编号 | BC002579 |
| 基因名称 | GCDH |
| Gene ID (NCBI) | 2639 |
| RRID | AB_2878092 |
| 偶联类型 | Unconjugated |
| 形式 | Liquid |
| 纯化方式 | Antigen affinity purification |
| UNIPROT ID | Q92947 |
| 储存缓冲液 | PBS with 0.02% sodium azide and 50% glycerol, pH 7.3. |
| 储存条件 | Store at -20°C. Stable for one year after shipment. Aliquoting is unnecessary for -20oC storage. |
背景介绍
GCDH is a nuclear-encoded mitochondrial protein involved in the catabolic pathway of tryptophan, lysine and hydroxylysine. The functional enzyme is a homotetramer of 43.3 kDa subunits that resides in the mitochondrial matrix. GCDH activity reduction leads to predominant accumulation of glutaric (GA) and 3- hydroxyglutaric (3HGA) acids in tissues, mostly brain, and biological fluids of affected patients. GCDH is widely expressed and has the highest levels in liver and kidney, which is consistent with its role in amino acid oxidation. (PMID: 27984186, 33001399)
实验方案
| Product Specific Protocols | |
|---|---|
| IHC protocol for GCDH antibody 14930-1-AP | Download protocol |
| WB protocol for GCDH antibody 14930-1-AP | Download protocol |
| Standard Protocols | |
|---|---|
| Click here to view our Standard Protocols |
发表文章
| Species | Application | Title |
|---|---|---|
Cancer Cell Inhibition of De Novo NAD(+) Synthesis by Oncogenic URI Causes Liver Tumorigenesis through DNA Damage. | ||
PLoS One Effects of targeted suppression of glutaryl-CoA dehydrogenase by lentivirus-mediated shRNA and excessive intake of lysine on apoptosis in rat striatal neurons. | ||
Mol Metab Dysregulated transmethylation leading to hepatocellular carcinoma compromises redox homeostasis and glucose formation. | ||
Front Pharmacol Proteomic analysis revealed the pharmacological mechanism of Xueshuantong injection in preventing early acute myocardial infarction injury |